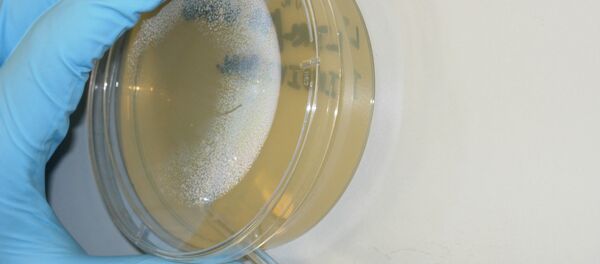
The bacteria, Burkholderia pseudomallei, primarily found in south-east Asia, was accidentally released from the Tulane National Primate Research Center in Louisiana. - Sputnik International

Five patients became ill with listeriosis between January 2014 and January 2015 after being hospitalized for unrelated conditions at the same hospital, three of whom died from the infection, which primarily affects older adults, pregnant women, newborns and adults with weakened immune systems.
According to a statement from the U.S. Food and Drug Administration on Friday, the patients fell ill after consuming milkshakes made with a single-serving of a product made by the Blue Bell ice cream brand, called "Scoops."
The manufacturer, Blue Bell Creameries, has withdrawn a number of products from sale which were manufactured using one of its machines on the production line at its factory in Brenham, Texas. "For the first time in 108 years, Blue Bell announces a product recall," said the company in a statement.
Listeriosis is a foodborne illness caused by Listeria monocytogenes, which unlike many other germs can grow even in the cold temperature of the refrigerator. Symptoms, which can begin from three up to 70 days after consuming the bacteria, include fever and muscle aches, sometimes preceded by diarrhea or other gastrointestinal symptoms; almost everyone who is diagnosed has 'invasive' infection, in which the bacteria spread beyond the gastrointestinal tract. Infection is treated with antibiotics, but even with prompt treatment some cases can result in death.